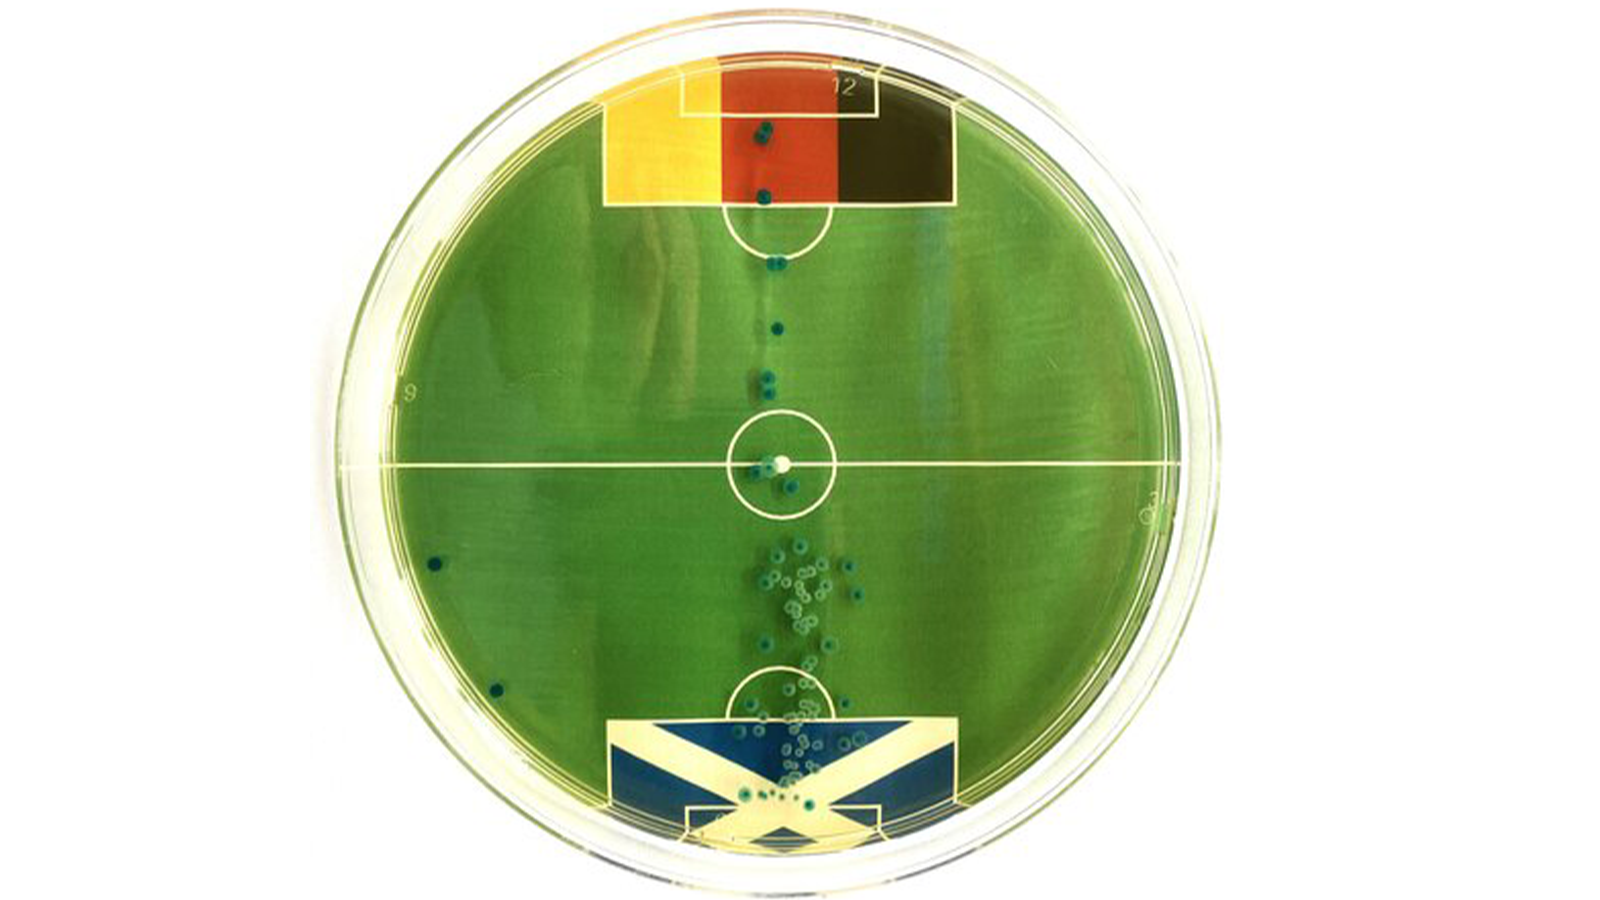
Bakterien

Bakterien als EM-Orakel?
Zur Fußball-EM 2024 in Deutschland setzen Wissenschaftler auf eine neue Orakel-Methode. Escherichia coli-Bakterien sollen den Ausgang der Spiele voraussagen.
Zur Fußball-EM 2024 in Deutschland setzen Wissenschaftler auf eine neue Orakel-Methode. Escherichia coli-Bakterien sollen den Ausgang der Spiele voraussagen.
Die Vorhersage von Fußballergebnissen durch Tiere wie Krake Paul und Elefantin Nelly hat Kultstatus erreicht. Zur Fußball-EM 2024 in Deutschland haben Wissenschaftler nun eine neue Methode: Escherichia coli-Bakterien sollen den Ausgang der Spiele voraussagen. Diese im menschlichen Darm vorkommenden Bakterien werden von deutschen Forschern jetzt auf eine ganz neue Weise genutzt.
Unter der Leitung von Mikrobiologe Prof. Dr. Markus Egert von der Hochschule Furtwangen wird der harmlose Laborstamm Escherichia coli K-12 eingesetzt. Für die Vorhersage werden die Bakterien in Petrischalen auf Abbildungen von Fußballfeldern gezüchtet. Die Verteilung der Bakterienherde auf dem Feld soll den Ausgang der Spiele zeigen. Die Idee zu diesem Projekt entstand aus der Begeisterung für frühere tierische Orakel wie den Kraken Paul. Egert betont, dass man mit seiner Forschungsdisziplin auch einmal Spaß haben dürfe. Normalerweise ist der Professor für seine Studien zur Keimbelastung von Haushaltsgegenständen bekannt.
Für das Eröffnungsspiel der deutschen Nationalmannschaft am 14. Juni gegen Schottland haben die Bakterien bereits eine Vorhersage getroffen. „Deutschland wird gegen Schottland gewinnen“, verkündet Egert. In der Petrischale wuchsen nach wenigen Tagen deutlich mehr Bakterien im schottischen Torraum als auf der deutschen Seite. „Das sieht vielversprechend aus“, kommentiert Egert.
Die Vorhersagen des „Bakterienorakels“ werden vor den Spielen der deutschen Nationalmannschaft auf den Social-Media-Kanälen der Hochschule Furtwangen veröffentlicht.
